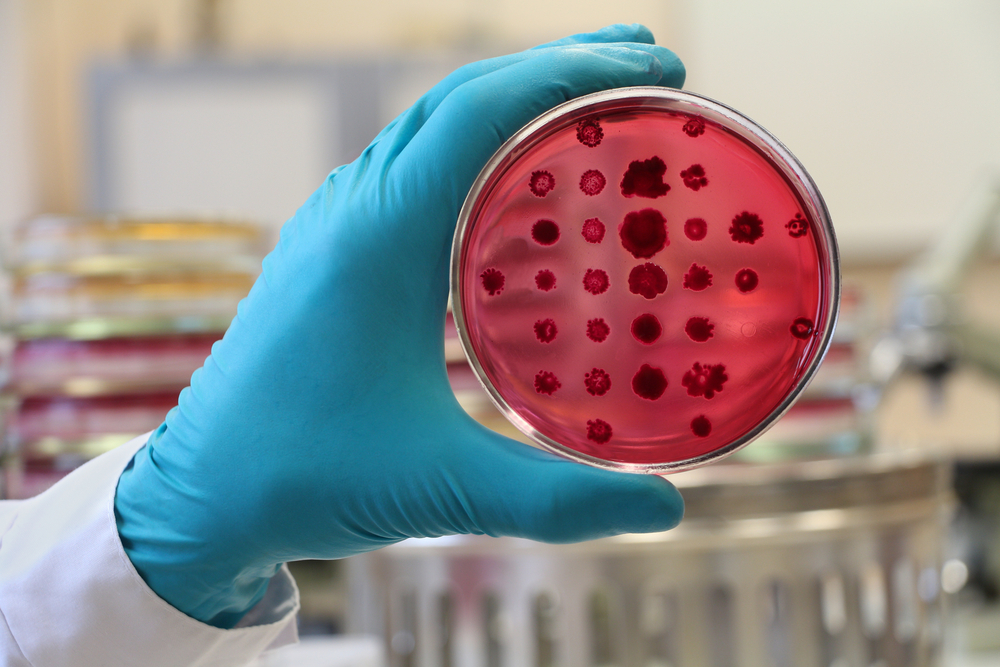

Zakladatel Playboye Hugh Hefner na konci září oficiálně zemřel kvůli srdeční zástavě a selhání plic. Podle úmrtního listu se ale týden před smrtí v těle 91letého vydavatele našly známky svědčící o infekci bakterií E. coli. Informuje o tom magazín People.
Podle serveru People byla na seznamu možných příčin Hefnerova úmrtí infekce E. coli potvrzena jako neznámá. Kromě ní se v jeho krvi našla také septikémie. „Septikémie je reakce těla na infekci, která vede k selhání orgánů,“ vysvětluje Pritis K. Tosh, který jako doktor a výzkumný pracovník v oblasti infekčních nemocí působí na klinice Mayo. Prakticky jde o to, že bakterie, které infikují jinou část těla, infiltrovaly do krevního oběhu a vyvolaly vážnou, život ohrožující reakci.
Rostoucí hrozba pro zdraví veřejnosti
Bakterie E. coli neboli Escherichia coli je jednou z těch, které způsobují infekce nereagující na léčbu. Ačkoliv jsou vzácné, pro zdraví veřejnosti představují rostoucí hrozbu. Podle amerického Centra pro kontrolu a prevenci nemocí způsobují některé kmeny E. coli průjem, infekci močových cest, pneumonii a další nemoci. Hefnerova E. coli je překvapující z jednoho důvodu – podle úmrtního listu totiž vytrvale odolávala léčbě antibiotiky.
Bakterie E. coli neboli Escherichia coli je jednou z těch, které způsobují infekce nereagující na léčbu. Ačkoliv jsou vzácné, pro zdraví veřejnosti představují rostoucí hrozbu.
E.coli odolávající antibiotikům znepokojuje lékaře
Případ E.coli rezistentní vůči antibiotikům je pro zdravotníky znepokojující. Jakmile totiž selže tento způsob léčby, jsou další možnosti téměř vyčerpány. „Skutečně přicházíme do styku s infekcemi, které na léčbu antibiotiky nereagují. V takových případech nejsme schopni předvídat, zda nějaké antibiotikum nakonec zabere či nikoliv,“ vysvětluje doktor Tosh.
Podle něj se většina lidí se střevní infekcí E. coli způsobující průjmy po několika dnech zlepší, je-li jim dodáván dostatek tekutin, které zabrání dehydrataci organismu. Závažnější infekce E. coli ovšem mohou vyžadovat antibiotika a v takové podobě potom vážně ohrožují život. Zejména tehdy, nejsou-li první prášky účinné. Což byl zřejmě i případ Hugha Hefnera. Když E. coli na léčbu nereaguje, mohou lékaři použít starší antibiotika. „Ty ale mohou být méně účinná a navíc toxická,“ varuje doktor Tosh.
Nedodržování léčby pomáhá bakteriím přežít
„O odolnosti bakterií vůči antibiotikům uvažujeme jako o mechanismu jejich přežití,“ vysvětluje doktor Tosh. Tento organismus si v průběhu času vyvinul rezistenci na léky určené k jeho zničení. Tomu částečně napomáhá i neodborná veřejnost, která antibiotika ne vždy užívá podle přesného doporučení lékařů. „Čím více druhů léků užíváme, tím více vlastně nutíme bakterie vytvářet protilátky a přežívat,“ říká k tomu doktor Tosh. „Pokud nebudeme přijímat kroky vedoucí k nápravě, ocitneme se nakonec ve stejném stavu, který zahájení léčby vyprovokoval.“

I když zní hrozba jménem E. coli zprvu strašidelně, snadno jí zabráníte už jen tím, že si budete mýt ruce.
Pozor na oslabení střevní mikroflóry
Případy odolnosti E. coli vůči antibiotikům jsou ale podle doktora Toshe zatím naštěstí vzácné. Bakterie se obvykle šíří kontaminovaným jídlem, vodou nebo přes nakaženou osobu a zřídkakdy ve střevech škodí. U většiny zdravých lidí totiž dobré střevní bakterie dokážou situaci velmi rychle dostat pod kontrolu. V případě nemoci, snížené imunity a užívání antibiotik je ale přirozená střevní mikroflóra oslabena. To dává E. coli vyšší šanci na přežití a spouští riziko vzniku vážných onemocnění.
Nepodceňujte očkování a myjte si ruce
Infekce odolné vůči antibiotikům jakéhokoliv druhu významně ohrožují naše zdraví. Naštěstí existují dvě jednoduché věci, které můžeme každý sám za sebe udělat v rámci prevence. Alespoň to tvrdí americké Centrum pro prevenci a kontrolu nemocí. Upozorňuje veřejnost nejen na význam očkování, ale také na důležitost pravidelné hygieny rukou. Ta prý významně snižuje šíření bakterií a nemocí, které způsobují.
foto: Shutterstock, zdroj: People



